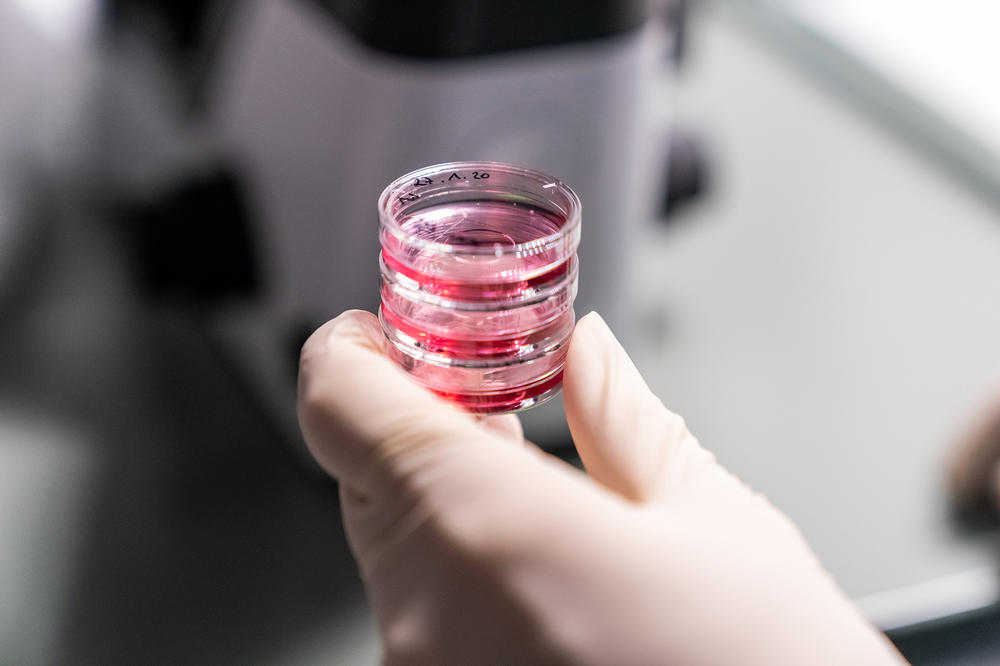
The researchers are analyzing tumor cell samples from the Charité biobank. They want to identify the molecular characteristics of tumors that have responded well to hyperthermia therapy.

Why Does Heat Help Combat Tumors?
Researchers from Freie Universität Berlin, Charité – Universitätsmedizin Berlin, and start-up Omiqa have teamed up to investigate how heat can be used to supplement tumor therapy
Dec 22, 2022
The researchers are analyzing tumor cell samples from the Charité biobank. They want to identify the molecular characteristics of tumors that have responded well to hyperthermia therapy.
Image Credit: Michael Fahrig
Heat was already used to cure illnesses way back in ancient Greece. It also plays an important role in the traditional medicines of other cultures. In modern medicine, heat or hyperthermia is sometimes used in cancer treatment. Scientists have long known that some tumors respond better where a combination of chemotherapy and heat is used instead of chemotherapy on its own, for example, through locally heating tissue to temperatures of up to 40 degrees Celsius. However, no one fully understands yet why heat only works on certain tumors, nor what goes on at a molecular level inside the cancer cells during treatment.
“Once we solve this puzzle and understand the mechanisms, we can very likely use hyperthermia in a more targeted and effective way,” says Florian Heyd, a biochemistry professor from the Institute of Chemistry and Biochemistry at Freie Universität. Professor Heyd heads a working group that has been researching the molecular impact of minor changes in body temperature. This fundamental research has also provided reference points indicating that the central regulators behind tumor development are influenced by temperature changes.
Higher Body Temperatures May Damage Tumors
The team has managed to demonstrate that the activity of the protein phosphatase PP2A, a known tumor suppressor, reacts strongly to temperature changes between 35 to 40 degrees Celsius. The protein becomes more active as the temperature rises. “In some cell types, the higher phosphatase activity leads to increased expression of the tumor suppressor p53 and a reduced expression of the oncogene Myc,” explains Heyd. Since p53 and Myc are among the most important factors in the formation of cancer cells, he surmises that higher body temperatures generally tend to damage tumors. Lower body temperatures, however, could benefit their growth.
“Our fundamental research has suddenly gained a clinical link thanks to this observation,” says Heyd. Together with Pirus Ghadjar, professor at the Hyperthermia Center at Charité – Universitätsmedizin Berlin, his working group has now started a new research project. They want to ascertain whether the laboratory findings can be used in the treatment of cancer patients. Furthermore, they are exploring whether the molecular composition of tumors indicates in advance that hyperthermia treatment promises success.
Identifying Molecular Characteristics
To reach their goal, the researchers are analyzing samples of tumor cells from the Charité biobank. They already know which of these samples have reacted positively to hyperthermia. “We hope to identify the molecular characteristics of tumors that have responded well or not at all to the treatment,” Alexander Neumann explains. Neumann, a postdoctoral researcher in biochemistry, is co-founder and managing director of Omiqa Bioinformatics, a start-up that is carrying out some of the complex bioinformatic analyses.
The project team makes use of next-generation sequencing to analyze a wide range of tumors. In contrast to previous familiar sequencing processes, this method allows several hundred million DNA fragments to be simultaneously sequenced in one sample. “We are paying attention to the known factors of PP2A, p53, and Myc, but will also be on the lookout for other, possibly previously unknown factors that may explain susceptibility to hyperthermia,” says Heyd.
Better Cancer Treatment Is the Aim
On the basis of these characteristics, doctors may in the future be able to determine whether a tumor should be treated with heat in addition to chemotherapy. “These individual therapy decisions, also known as personalized medicine, will soon become part of clinical practice. They could help improve the treatment of patients in many areas, including hyperthermia,” says Professor Ghadjar.
“In this project, the science location of Berlin can truly play to its strengths,” Heyd notes. The expertise his working group possesses in fundamental academic research ideally complements that of their clinical research colleagues from Charité and the know-how at start-up Omiqa Bioinformatics.
Omiqa founders Tom Haltenhof, Alexander Neumann, and Didrik Olofsson carried out research work together for several years at the Institute of Chemistry and Biochemistry at Freie Universität Berlin. At their start-up, they combine state-of-the-art bioinformatics with a client-driven approach to develop purpose-built analysis solutions. The team set up shop in 2020 after being awarded an EXIST start-up grant by the Federal Ministry for Economic Affairs and Climate Action. They also received support from Profund Innovation at Freie Universität Berlin.
The German Research Foundation has allocated a total of 500,000 euros to fund the project aimed at identifying molecular mechanisms in tumor hyperthermia therapy.
This article originally appeared in German on December 5, 2022, in campus.leben, the online magazine of Freie Universität Berlin.
Further Information
- Prof. Dr. Florian Heyd, Email: florian.heyd@fu-berlin.de
- Website: https://omiqa.bio/
Further articles on this topic:
- A Small Difference: Children are less likely to become seriously ill with Covid-19 due to higher body temperature, February 22, 2022
- Die nächste Generation der Genom-Analyse (“The Next Generation of Genome Analysis,” in German): The start-up Omiqa Bioinformatics is developing a platform for the analysis of genomic data, July 22, 2020